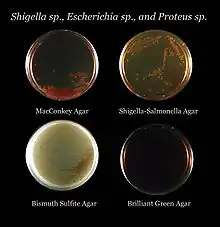

Placa de agar
Una placa de agar (también, plato de agar) es una placa de Petri que contiene un medio de cultivo (comúnmente agar además de nutrientes) usada en microbiología para cultivar microorganismos o pequeñas plantas como la briofita Physcomitrella patens. Se pueden agregar compuestos como antibióticos, para hacer el medio selectivo.[1]

Al colocar microorganismos individualmente en la placa crecerán en colonias individuales. Cada réplica del microorganismo es seguramente idéntico genéticamente a su antecesor (excepto por la baja e inevitable tasa de mutación). Por lo tanto, la placa se puede usar para estimar la concentración de microorganismos en un cultivo o una solución de ese cultivo, usando un contador de colonias. También se puede usar para generar cultivos genéticamente puros a partir de un cultivo mixto, con diferentes especies de microorganismos, usando una técnica llamada «estriado». En esta técnica, una gota del cultivo es tomada de la muestra, mediante un instrumento llamado «asa bacteriológica», estéril; después se distribuye la muestra sobre la superficie del medio de cultivo dibujando estrías (de ahí el nombre), dejando de esta forma un gran número de microorganismos al principio y una baja cantidad al final de colonias aisladas. Luego, las colonias que crecieron pueden removerse individualmente con otra asa estéril, y así determinar a qué especie corresponde cada colonia individual. Este método es además, usado prácticamente en todos los laboratorios de microbiología para hacer cualquier cultivo bacteriológico.[1]
Historia
En 1881 Walther Hesse, esposo de Angelina Fannie, se dio cuenta de que la gelatina y budines que hizo su esposa no se derretían a temperatura elevada, preguntándole a Fannie a que se debía y ella le comenta que empleó agar para su preparación. Gracias a ello Hesse sugirió el agar como una sustancia ideal para medio de cultivo, por sus usos en la cocina de su esposa.
Tipos

Como otros medios de cultivo, las formulaciones de agar usadas en places pueden ser clasificadas como definidos e indefinidos. Un medio definido es aquel creado a partir de sustancias químicas individuales, requeridas específicamente por el microorganismo, así que la composición molecular exacta es conocida; mientras que un medio indefinido está hecho de productos naturales, donde la composición exacta es desconocida.[2]
Las placas de agar pueden ser elaboradas como no selectivas, donde puede crecer cualquier organismo sin especificación, o pueden ser selectivas, donde solo crecen organismos específicos.[3] Esta especificidad, puede ser por un requerimiento nutricional (por ejemplo lactosa como única fuente de carbono, permitiendo crecer de esta manera solo microorganismo capaces de metabolizar lactosa), o agregando antibióticos u otras sustancias con el fin de volver al medio selectivo. Esto se relaciona con las definiciones de medios definidos e indefinidos; los medios indefinidos hechos de productos naturales, contienen una gran variedad de moléculas orgánicas, y es más permisivo en sentido que provee de nutrientes a una amplia gama de microorganismos, mientras que los medios definidos pueden ser precisamente elaborados para seleccionar microorganismos con propiedades específicas. Las placas de agar, también actúan como indicadores, donde los organismos no son seleccionados en base al crecimiento, sino por un cambio de color en algunas colonias, generalmente causada por la acción de una enzima del microorganismo, sobre un componente del medio. Algunos tipos de places de agar utilizadas son:

Agar sangre
- Agar sangre
Contiene sangre de mamíferos (generalmente oveja, conejo, humanos) a una concentración de 5 a 10%. El agar sangre, es un medio enriquecido, diferencial, usado para aislar microorganismos fastidiosos y detectar actividad hemolítica. La β-hemolisis, se manifiesta como una lisis y digestión completa de los eritrocitos que rodean la colonia, por ejemplo algunas bacterias del género Streptococcus. La α-hemolisis , aparece solo como lisis parcial (los eritrocitos, no son lisados completamente o la digestión no fue completa), por tanto la hemoglobina aparece como un halo verdoso alrededor de la colonia. Contiene extracto de carne, triptona, cloruro de sodio y agar.
Es un tipo de agar sangre, donde las células sanguíneas han sido lisadas por calentamiento a 56 °C. El agar chocolate se usa para cultivo de bacterias respiratorias fastidiosas como por ejemplo Haemophilus influenzae. No contiene chocolate, solo es llamado así por la coloración.
- Agar Thayer-Martin
agar chocolate diseñado para aislar Neisseria gonorrhoeae.
- Agar TCBS
TCBS (Tiosulfato-Citrato-Bilis-Sacarosa,)- agar enriquecido, permite el crecimiento de todos las especies patógenas del género Vibrio spp.[4]
Medios bacteriológicos de uso general
- Agar bilis esculina con azida
Es usado para aislar Enterococcus así como Streptococcus
- Agar CLED (Agar cistina-lactosa deficiente en electrolitos)
es un medio de cultivo diferencial para aislar y contar las bacterias presentes en la orina. Favorece el crecimiento de los patógenos y contaminantes urinarios aunque, debido a la ausencia de electrolitos, impide la indebida proliferación de especies de Proteus
- Agar entérico de Hektoen
Este es un medio ideal para el aislamiento selectivo de Salmonella y Shigella, a partir de heces y alimentos.
Este medio se utiliza para el aislamiento de bacilos Gramnegativos de fácil desarrollo, aerobios y anaerobios facultativos. Permite diferenciar bacterias que fermentan lactosa (L+) de las no fermentadoras (L-) en muestras clínicas, de agua y alimentos. Todas las especies de la familia Enterobacteriaceae se desarrollan en el mismo. Contiene sales biliares y cristal violeta, lo que inhibe el crecimiento de bacterias Grampositivas, lo que convierte en un medio diferencial poco selectivo.
Medio de cultivo selectivo y diferencial, utilizado para el aislamiento y diferenciación de estafilococos. Es recomendado para el aislamiento de estafilococos patogénicos a partir de muestras clínicas, alimentos, productos cosméticos y otros materiales de importancia sanitaria.
Este medio también puede utilizarse para el cultivo de especies halófilas de Vibrio, si no se dispone de medios apropiados (TCBS Medio, Medio Marino, etc.), aunque algunas especies pueden no desarrollar.
- Agar Mueller-Hinton
Este medio de cultivo ha sido recomendado universalmente para la prueba de sensibilidad a los antimicrobianos. Además es útil con el agregado de sangre para el cultivo y aislamiento de microorganismos nutricionalmente exigentes.
Medio de cultivo utilizado para propósitos generales, para el aislamiento de microorganismos poco exigentes en lo que se refiere a requisitos nutricionales. Su uso está descripto en muchos procedimientos para el análisis de alimentos, aguas y otros materiales de importancia sanitaria.
- Agar Önöz
El agar Önöz permite un diagnostic bacteriológico rápido de Salmonella y Shigella Las colonias son fácilmente diferenciables de otras enterobacterias.
- Agar Feniletil alcohol
Este agar selecciona especies de Staphylococcus mientras inhibe bacilos gamnegativos como Escherichia coli, Shigella, Proteus, etc.
- Agar R2A
Un agar inespecífico que imita el agua. Usado para análisis del agua.
- Agar Tripticasa soya (TSA)
TSA es una medio multiuso, producido por la digestión enzimática de soya y caseína. Es la base de otros tipos de agar, por ejemplo el agar sangre está hecho de TSA enriquecido con sangre. TSA permite crecer muchas bacterias semifastidosas incluyendo algunas especies de Brucella, Corynebacterium, Listeria, Neisseria, y Vibrio.
- Agar Xilosa, Lisina, Desoxicolato
es utilizado para el aislamiento y diferenciación de bacilos entéricos Gramnegativos, especialmente del género Shigella y Providencia.
- Agar cetrimida
Medio utilizado para el aislamiento selectivo de Pseudomonas aeruginosa y de otras especies del género Pseudomonas.
- Agar Tinsdale
Contiene telurito de potasio y puede aislar Corynebacterium diphteriae.[5]

Medios para hongos
- Agar glucosado de Sabouraud
el Agar glucosado de Sabouraud es usado para cultivar hongos y tiene un pH bajo que inhibe el crecimiento de la mayoría de bacterias, además tiene un antibiótico (gentamicina) que inhibe específicamente el crecimiento de bacterias gramnegativas .
- Agar Infusión Cerebro Corazón
Es un medio muy rico en nutrientes, que proporciona un adecuado desarrollo microbiano. La infusión de cerebro de ternera, la infusión de corazón vacuno y la peptona, son la fuente de carbono, nitrógeno, y vitaminas. La glucosa es el hidrato de carbono fermentable, el cloruro de sodio mantiene el balance osmótico y el fosfato disódico otorga capacidad buffer.
es un medio utilizado para el cultivo de hongos y levaduras a partir de muestras de alimentos, derivados de leche y productos cosméticos.
- Agar extracto de malta
Tiene un alto contenido de peptona.
Véase también
Referencias
- Madigan M, Martinko J (editors). (2005). Brock Biology of Microorganisms (11th ed. edición). Prentice Hall. ISBN 0131443291.
- Baron S et al., (editors). (1996). Baron's Medical Microbiology (4th ed. edición). University of Texas Medical Branch. (via NCBI Bookshelf) ISBN 0-9631172-1-1.
- Ryan KJ; Ray CG (editors) (2004). Sherris Medical Microbiology (4th ed. edición). McGraw Hill. ISBN 0838585299.
- Fisher, Bruce; Harvey, Richard P.; Champe, Pamela C. (2006). Lippincott's Illustrated Reviews: Microbiology (Lippincott's Illustrated Reviews Series). Hagerstwon, MD: Lippincott Williams & Wilkins. ISBN 0-7817-8215-5.
- Fisher, Bruce; Harvey, Richard P.; Champe, Pamela C. (2006). Lippincott's Illustrated Reviews: Microbiology (Lippincott's Illustrated Reviews Series). Hagerstown, MD: Lippincott Williams & Wilkins. p. 338. ISBN 0-7817-8215-5.
